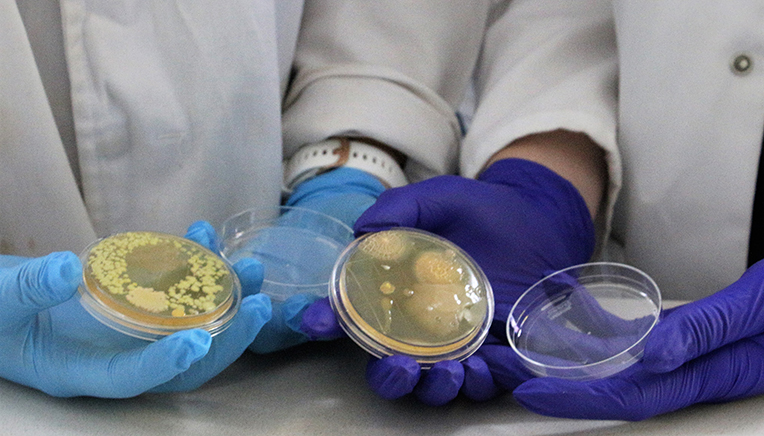

Opinion article by Prof Robert Bragg, Wanja Swart, and Samantha Mc Carlie, Infection Control Group within the Veterinary Biotechnology Research Group, Department of Microbiology and Biochemistry, University of the Free State.
The storm is coming, and it has, in fact, already had significant effects in health care and agriculture. This is the storm of resistance to disinfectants.
In the age where antibiotics are ever decreasing in efficacy and the search for novel antimicrobials is not progressing very well, our last line of defence against bacterial diseases is biosecurity. Biosecurity is the concept of preventing the infection before the individual becomes infected. The individual can be human, animal or plant. The main weapons in the arsenal for good biosecurity are disinfectants and sanitisers, of which there are many. In fact, way too many! Many of these disinfectants are not used correctly, and in many cases, there is no effort to monitor the efficacy of the disinfectants used in a particular situation. Many of these are not registered for use and have never been tested in a clinical setting. This is a big part of the problem.
Antibiotic resistance is a well-known global crisis currently challenging the healthcare community. However, the COVID-19 pandemic has highlighted our reliance on disinfectants and sanitisers as infection control measures. In 2020 alone, it was estimated that 700 000 tons of quaternary ammonium compound (QAC)-based disinfectants were released into the environment. The presence of these disinfectants environmentally leads to selection for resistant microorganisms and can lead to the development of resistant populations in our water systems, on farms, and around hospitals. This has prompted the Infection Control research group at the UFS to explore new research regarding microbial resistance to disinfectant and sanitiser compounds, as well as whether resistance to disinfectants and antibiotics is linked.
The coming storm in health care
Nosocomial infections, otherwise known as hospital-acquired infections (HAIs), affect 30% of ICU patients in high-income countries and up to 70% in low-income countries, with more than 52% of these infections being fatal. According to the
World Health Organisation (WHO), HAIs are also responsible for up to 56% of all deaths in neonates.
In 2014, an article was published with a powerful title: The future if we do not act now, where the author stated that if we do not address antimicrobial resistance (AMR), it will be responsible for the death of 10 million individuals by the year 2050, which would make it a bigger killer than cancer today. This information was widely regarded as an over-dramatisation as, at the time, AMR was estimated to have claimed the lives of 700 000 individuals annually. However, the WHO estimated that AMR was directly responsible for 1,27 million deaths in 2019 and 4,95 million deaths in 2022. It is now becoming abundantly clear that this article was not an over-dramatisation, and the number of 10 million mortalities will be reached long before 2050. We are already halfway there in 2022.
With health care being the environment where most cases of AMR and HAIs occur in conjunction, it is concerning that research is underway that shows exponential increases in resistance when bacteria are exposed to sub-minimum levels of disinfectants regularly used within the health-care setting.
The coming storm in agriculture
The need to reduce the use of antibiotics in agriculture has been in place for several years now. The concept of biosecurity is well established in the agricultural sector, but disinfectants are still being misused. It is difficult to produce meat products without the use of antibiotics; this will result in an increase in the cost of meat products, which will put it beyond the reach of many people. Good biosecurity is essential in the animal production area, and this research group has been working in the area for many years. The experience gained in this field is now being applied to the healthcare setting. If we can reduce mortalities in a poultry pen by 56% through good biosecurity prevention practices, it should certainly be possible to achieve similar or much better results in the health-care sector.
Research on the mechanisms of disinfectant resistance
Current projects in
Prof Robert Bragg’s laboratory include a PhD by
Samantha Mc Carlie, investigating how bacteria become resistant to disinfectant and sanitiser products. A highly resistant ‘superbug’ bacterium related to Serratia marcescens has been discovered, and Mc Carlie is working with this isolate to determine the reason for the high level of resistance to disinfectant and sanitiser products. This work is being done on a genetic level to reveal which resistance genes and metabolic systems are responsible for high levels of antimicrobial resistance. Master of Science (MSc) projects by
Boudine van der Walt and
Wanja Swart are investigating how disinfectant resistance is transferred between bacterial species, and whether disinfectant resistance and antibiotic resistance are linked.
Wanja Swart’s MSc project focuses on investigating the simultaneous development of antibiotic and disinfectant resistance within one bacterium. Resistance occurs despite the absence of one of these products in a familiar nosocomial pathogen, Serratia marcescens. Gene-based analysis will shed light on how these mechanisms present on a genetic level. In addition, resistance to disinfectants and antibiotics may be inducted to higher levels, which could provide new insights to just how dangerous incorrectly used disinfectants can be.
Gunther Staats has just completed yet another MSc project, focusing on efflux pumps that pump out antimicrobial agents from the inside of bacterial cells.
Evaluation of the efficacy of disinfectants
Registration of disinfectants, where applicable, has specific guidelines according to which bacterial pathogens need to be tested against these products. The required cultures are generally environmental reference ATCC (American type culture collection) strains, which ensure consistency and fair treatment when doing product registration.
However, the situation in the field, farm, or hospital ward may be very different. The pathogens that are found in these settings may be totally different from the ATCC strains, as they are regularly challenged with disinfectants and antibiotics.
Work performed by Wanja Swart showed that in just 10 consecutive days of exposure to disinfectants, resistance to commonly used disinfectants can increase 32-fold. So why is this important? Firstly, accurate dilution of disinfectants appears to be a challenge for many, so the likelihood of the products being used correctly is relatively small. Also, some of the products have substantial residual activity on surfaces. This will result in the exposure of bacteria to sub-lethal levels for extended periods of time as well as a build-up of disinfectant – which will in turn result in a further increase in resistance.
Research outputs so far for 2023 include two publications by Samantha Mc Carlie on bacterial resistance to disinfectants in the accredited peer-reviewed journal, Microorganisms, titled ‘Genomic Islands Identified in Highly Resistant Serratia sp. HRI: A Pathway to Discover New Disinfectant Resistance Elements’ and ‘The Hermetic Effect Observed for Benzalkonium Chloride and Didecyldimethylammonium Chloride in Serratia sp. HRI’. In addition, three book chapters have been published in the book Antimicrobial Resistance and One Health in Africa by Springer Publishers, titled ‘Biosecurity and Disinfectant resistance in a Post-antibiotic era’, ‘The Linkage between Antibiotic and Disinfectant Resistance’, and ‘The Current State of Antimicrobial resistance in Bovine Mastitis in Various African Countries’.